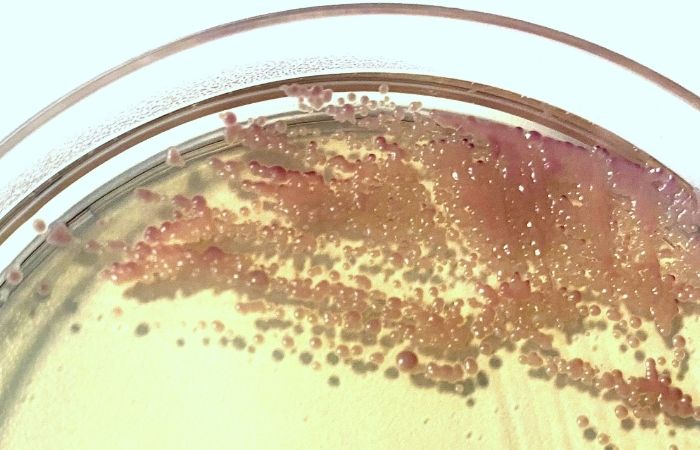

Skin Rash and STDs: Symptoms, Types, Differentiation
Imagine borrowing a pair of cute lace panties from your bestie after an unexpected sleepover. You toss them on without a second thought, no big deal, right? It’s not like you’re swapping spit or doing anything that intimate. But what if I told you that slipping into someone else’s underwear could be a silent, skin-tight gamble with your sexual health?
Yep. That little moment of convenience or closeness might carry more than cozy cotton, it could come with creepy crawlies, microscopic invaders, and infections that don’t give a damn about your friendship. Because here’s the uncomfortable truth: while it’s rare to catch an STI from clothing, shared underwear is a unique and intimate vector that deserves way more attention than it gets.
So, if you’ve ever slipped into a pair of borrowed briefs, or passed around laundry-day backups in a pinch, this is your wake-up call. We're going deep, into the science, the rumors, the risks, and the very real infections that can cling to cloth and follow you home. Grab a seat (preferably one that’s clean), and let’s talk about what actually happens when you share underwear.

The Dirty Details, Can You Really Get an STI from Shared Underwear?
Let’s start with a truth bomb: most STIs don’t survive well outside the human body. Bacteria like gonorrhea and chlamydia need moisture and warmth, which fabric doesn't offer for long. So if you’re terrified that your friend’s panties are carrying active herpes or syphilis bacteria days after they wore them, breathe.
But that doesn’t mean all is safe in the land of lace and elastic. There are a few sneaky little infections that can and do survive on fabrics, particularly underwear. Here’s the not-so-fun lineup:
- Pubic lice ("crabs"): These parasitic insects love coarse hair and can cling to underwear fibers, waiting for a new host.
- Scabies: Caused by microscopic mites that burrow into the skin. They can live on fabric for up to 3 days.
- Molluscum contagiosum: A viral skin infection that causes small, raised lesions, and yes, it can spread through shared clothing or towels.
- Fungal infections (like jock itch or yeast): While not technically STIs, these thrive in warm, damp undies and can absolutely be passed from person to person through fabric contact.
While viral and bacterial STIs like HIV, gonorrhea, or chlamydia are unlikely to be transmitted this way, skin-to-skin STIs and parasitic infections are the exception. Underwear is a high-contact garment, directly against genitals, absorbing sweat, vaginal fluids, semen, and microscopic skin debris. This is not a clothing item you want to be casual with.
Order Now $75.00 $98.00 Check Your STD Status in Minutes
Test at Home with Remedium
Genital & Oral Herpes Test Kit




For all 2 tests
Why It’s More Common Than You Think, And What Makes It Risky
Let’s be honest. The idea of sharing underwear sounds gross in theory, but in practice? It happens all the time.
- You’re on vacation, your luggage gets lost.
- You sleep over and didn’t pack a fresh pair.
- Your hookup offers you something “clean” from their drawer.
- Your best friend gives you a backup thong for a last-minute outfit change.
These moments don’t feel dangerous, they feel friendly, spontaneous, or even sexy. And that’s where the risk hides. Because it doesn’t feel risky, no one thinks to take precautions. And here’s the kicker: even if the underwear looks clean, it may not be sanitized. Most parasites and fungi aren't visible to the naked eye. Pubic lice, for instance, are about 1–2 mm in size. Scabies mites are even smaller, microscopic, in fact.
And washing underwear at lukewarm temperatures? Doesn’t always kill them. You’d need to launder at high heat (at least 130°F or 54°C) to reliably destroy these bugs. If your friend uses a gentle cycle or skips the dryer? That fabric might be bug central.
What’s more, if someone is asymptomatic (which is common with molluscum, scabies, or even early-stage lice), they might not even know they’re carrying something, and unknowingly pass it along.
The Itchy Truth, Infections You Can Actually Catch
Let’s zoom in on the infections that are most likely to hop a ride on your borrowed briefs. We’re not just fearmongering, we’re unpacking the real deal here:
Pubic Lice (Crabs)
Pubic lice are tiny insects that live in pubic hair and feed on human blood. They're transmitted through close contact, and yes, they can survive for 1–2 days on clothing or bedding.
Symptoms include:
- Intense itching
- Small blue spots where the lice have bitten
- Visible nits (eggs) or crawling lice in hair
Sharing underwear is a fast pass for pubic lice to find new real estate.

Scabies
Caused by mites that burrow under your skin to lay eggs. They can live on clothes for up to 72 hours if not properly washed.
Symptoms include:
- Red, itchy rash
- Burrow tracks on the skin
- Worst itching at night
If someone with scabies wore those undies, and you slipped into them the next day? Game over.
Molluscum Contagiosum
This viral infection causes pearl-like bumps on the skin and is spread through skin-to-skin contact or contaminated objects, including underwear.
Symptoms include:
- Small, firm, flesh-colored bumps
- May appear on thighs, genitals, or buttocks
- Can take weeks to develop
It’s often mistaken for razor burn or pimples, and it’s incredibly contagious.
Fungal Infections
Yeast infections or jock itch can be spread through shared damp underwear, especially if the person wore them while sweaty or post-gym.
Symptoms vary but often include:
- Itching or burning
- Redness and irritation
- Peeling or cracked skin
These are treatable, but that doesn’t mean you want them.
Order Now $49.00 $98.00 Check Your STD Status in Minutes
Test at Home with Remedium
Hepatitis B & Hepatitis C Test Kit




For all 2 tests
Prevention, Because "Just Don't Share" Isn’t Always Enough
So, what’s the play here? Never borrow clothes again? Burn your laundry pile and start fresh?
Not quite. Here’s how to protect yourself, even if you’re in a pinch:
- Avoid sharing underwear, full stop: Even if it’s “clean.” Even if it’s “just for an hour.” Even if it’s your bestie, your boo, or your sibling. Just don’t do it.
- Always wash new or borrowed clothing before wearing: Use hot water (at least 130°F) and high-heat drying to kill bacteria, mites, and lice.
- Know the symptoms of skin-contact STIs and infection: If you notice a rash, itching, or bumps in your genital area, don’t ignore it. These are signs your skin is trying to warn you.
- Use at-home STI test kits regularly: Especially if you’ve had potential exposure. STD Rapid Test Kits offers fast, private, and accurate tests you can take from home. No awkward clinics. No judgment. Just answers.
- Be open about hygiene with people you’re intimate with: It might feel awkward, but if you’re close enough to share drawers, you’re close enough to talk hygiene.
How Long Can STIs Live on Fabric? Here's What the Science Says
It’s easy to imagine underwear as harmless once it’s off a body. Out of sight, out of threat, right? Not so fast. Let’s take a deeper look into how long different pathogens can survive on clothing, and why underwear, specifically, is the perfect storm of conditions for short-term transmission.
Scabies Mites
Scabies mites can live up to 72 hours on fabrics like underwear, towels, and bedding. That means if you share underwear that was worn in the last 2–3 days by someone infected, those microscopic mites could still be alive and ready to burrow into your skin.
Pubic Lice
Pubic lice die quickly without a host, usually within 24–48 hours. However, nits (lice eggs) can cling to fabric for up to 7 days, hatching after they’re already on a new person.
Molluscum Contagiosum Virus
This virus lives outside the body on fabric for hours to days, especially in warm, moist environments like gym bags, towels, and, you guessed it, underwear.
Yeast and Fungal Spores
Fungi like Candida albicans (yeast) and Trichophyton rubrum (jock itch) can linger on damp fabrics for days, even longer in humid environments. If the underwear wasn’t fully dried or was worn during exercise, the spores might still be active.
These timelines make one thing clear: "It looks clean" doesn’t mean "It’s safe." Bacteria and parasites don't need visible residue to do damage. Especially in the dark, moist fabric of tight-fitting underwear, they can remain viable just long enough to ruin your week, or your next partner’s.
What Doctors Say , Expert Opinions on the Underwear Sharing Dilemma
While many health professionals downplay the likelihood of STI transmission through clothing in general, they make strong exceptions when it comes to intimate apparel. Here’s what the experts say:
“Underwear comes into direct contact with genital secretions, skin, and sometimes even blood. Sharing them, even briefly, is like sharing a toothbrush. It’s an intimate item and should be treated as such.”
Dr. Nina Patel, OB-GYN and public health researcher
“We see pubic lice, scabies, and molluscum contagiosum passed through clothing all the time. It’s not as common as skin-to-skin, but it happens more often than most people think.”
Dr. Luis Herrera, dermatologist and STI specialist
There’s also a pattern doctors report with patients:
- People don’t make the connection. They get a strange rash or itching and never think to mention that they borrowed someone’s clothing.
- Infections go unreported. Most people are too embarrassed to admit they shared underwear, even to doctors, so the transmission method gets overlooked.
- Hygiene shame stops conversations. But silence only leads to repeated cycles of infection and misdiagnosis.
It’s not about fear. It’s about awareness. And once you know what’s possible, you can protect yourself, and your partners, without paranoia.
Order Now $129.00 $343.00 Check Your STD Status in Minutes
Test at Home with Remedium
7-in-1 STD Test Kit




For all 7 tests
How Did We Get Here? A Brief History of Underwear and Health
Underwear hasn’t always existed. In fact, until the 20th century, many people went commando under long skirts or trousers. But as underwear became standard and fabrics more intimate, health conversations followed.
In the early 1900s, wool “drawers” were often shared among siblings or between soldiers. It wasn’t until medical authorities during World Wars I and II saw lice infestations among troops that personal undergarments began to be treated as individual essentials, not communal items.
Fast forward to today, our underwear is thinner, tighter, synthetic, and more body-hugging than ever before. Combine that with synthetic fabrics (which trap moisture), gym culture, and hookup apps... and we’ve created the perfect petri dish in our pants.
The culture of casual borrowing, especially among teens and women in tight-knit friend groups, has normalized sharing that should really never be normalized. What started as a gesture of closeness has morphed into a silent hygiene hazard.
The Future of Underwear Hygiene, What’s Coming Next?
With the rise of at-home STI testing, wearable health tech, and antimicrobial fabrics, we’re at a turning point in how we treat our underwear, not just as fashion, but as a part of our health regimen.
Here’s what might be around the corner:
- Underwear made with silver-infused fabrics that resist bacterial growth
- Disposable or biodegradable underwear for emergency use while traveling
- AI-powered laundry machines that detect pathogens and auto-adjust wash settings
- More widespread use of personal hygiene education, especially in schools and sex-ed programs, that finally include clothing hygiene
And the quiet revolution? Home testing kits. These kits give people the ability to test privately, discreetly, and regularly, closing the gap between exposure and awareness.
Because the future of sexual health isn’t just about condoms and conversations, it’s about what touches our skin every single day. And yes, that includes the thong you almost borrowed after brunch.

How to Apply This Knowledge , Real-World Scenarios and Smart Choices
It’s one thing to know the risks. It’s another to actually change habits. So let’s look at how this underwear-sharing cautionary tale plays out in real life, and what smart choices can protect you.
Scenario 1: The Sleepover Scramble
You’re at your friend’s house after a party. You didn’t plan to stay, and your only option is a loaner pair of underwear from her drawer.
Better move: Go commando in your own (clean) pants or ask for a clean pair of shorts instead. It’s far safer than putting on someone else’s undergarments.
Scenario 2: The Gym Bag Mix-Up
You grab your gym bag and realize your roommate’s underwear is inside. You’re late for your spin class. Do you wear it?
Better move: Absolutely not. Tight, sweaty workout gear is a breeding ground for fungi and mites. Stick with your outerwear or buy a cheap emergency pair from a nearby store.
Scenario 3: The Steamy Sleep-In
You crash at a hookup’s place. They offer you “a clean pair” of their underwear to wear to bed.
Better move: Unless you’ve had a conversation about hygiene, and trust their laundry routine, just don’t. Stick with your own clothes. Sexy doesn’t mean unsafe.
These may seem like small moments, but they add up. Sharing underwear might not feel intimate, but your genitals know better. They’re absorbing whatever those fibers carry, good, bad, or infectious.
Order Now $33.99 $49.00 Check Your STD Status in Minutes
Test at Home with Remedium
Hepatitis C Test Kit




Why It Matters Across Industries , The Broader Impact of Underwear Hygiene
The issue of underwear hygiene might seem personal, but it affects multiple industries, from healthcare to fashion to travel and hospitality.
In Healthcare
Clinics regularly treat conditions like molluscum, scabies, and fungal infections that could have been avoided with better clothing hygiene education. Infections spread through shared clothing cause misdiagnoses and often get labeled as STIs, which can carry heavy stigma.
In the Fashion Industry
Brands are increasingly being held accountable for hygiene in fitting rooms, with some stores implementing protective liners or banning try-ons of intimate items altogether. It's a growing conversation, and more designers are investing in antimicrobial fabrics.
In Travel and Hospitality
Hotels, hostels, and Airbnb rentals that offer “loaner” underwear or pajamas pose a quiet but real risk. Many travelers don’t realize that even laundered garments can carry fungi or mites if improperly sanitized.
In Education
Sex-ed curricula rarely cover clothing hygiene, but they should. The simple lesson of “don’t share underwear” is as important as teaching about condoms or STDs.

“I Didn’t Know Until It Itched”, Real Stories, Real Consequences
Case Study: Jade, 22 , “I just thought it was razor burn.”
Jade borrowed a friend’s thong after a pool party. “It looked clean, and I trusted her,” she said. A week later, she had an itchy rash on her thighs and red bumps on her bikini line. “I thought it was razor burn, but it spread.”
Diagnosis? Molluscum contagiosum. She was mortified, especially since she hadn’t had sex in over a month. The doctor told her it was likely from contaminated fabric. “I was shocked. No one talks about this.”
Case Study: Malik, 28 , “I shared gym shorts. That’s it.”
Malik borrowed a pair of gym shorts from a friend during a weekend trip. Two days later, the itching started. “I didn’t even think about it being an STI. I wasn’t even hooking up with anyone.”
Turned out to be scabies, and it took three weeks and two rounds of treatment to fully clear. “I’ll never wear someone else’s clothes again. I don’t care how close we are.”
These are just two of thousands of cases where people discover too late that you don’t need sex to get an STI-related infection. You just need fabric that’s been there before you.
Check Your STD Status in Minutes
Test at Home with RemediumHepatitis B Test Kit

 For Men & Women
For Men & Women Results in Minutes
Results in Minutes No Lab Needed
No Lab Needed Private & Discreet
Private & DiscreetOrder Now $33.99 $49.00
Mythbusting, Common Misconceptions About STIs and Underwear
Let’s burn these myths once and for all:
“You can’t get STIs without sex.”
Wrong. Skin-to-skin contact, shared clothing, towels, and even razors can transmit certain STIs and related infections.
“Clean underwear means safe underwear.”
Not if it wasn’t washed properly. “Clean” doesn’t equal sterile. Parasites and fungi can survive lukewarm washes.
“Only girls share underwear.”
Incorrect. Guys share gym gear, swim trunks, and boxers all the time. The risk doesn’t discriminate.
“If you don’t have symptoms, you’re fine.”
Many infections (molluscum, scabies, lice) don’t show symptoms right away, and some people are asymptomatic entirely.
“STIs can’t survive on fabric.”
Some can. Pubic lice, scabies, and molluscum contagiosum love soft, damp fabric like tight underwear and bathing suits.

FAQs
1. Can I get an STD from trying on underwear at a store?
The risk is extremely low if the underwear is new and you’re wearing a barrier (like underwear underneath or a liner). But yes, in theory, if someone with a contagious skin infection tried it on first and you wore it without protection… it’s possible. Always wear something underneath when trying on intimates.
2. My friend gave me “clean” underwear after a sleepover. Should I be worried?
If it’s freshly laundered with hot water and dried on high heat, the risk is low, but not zero. If they didn’t wash it well or wore it recently, there could be lingering parasites or fungi.
3. Can herpes live on underwear?
Herpes needs direct skin-to-skin contact to spread. It dies quickly outside the body, so transmission through underwear is very unlikely. However, if there were open sores and fresh fluid involved, the risk ticks up, so still, no sharing.
4. I borrowed a swimsuit bottom, am I at risk for anything?
Potentially, yes. Swimsuits can trap moisture and bacteria. If it wasn’t properly sanitized, there’s a chance of yeast, molluscum, or skin parasites transferring. It’s always better to bring your own.
5. What if I only wore the underwear for a few minutes?
Duration matters, but it’s not a guarantee of safety. Mites like scabies can transfer quickly. If there was close skin contact, the risk is still there.
6. Can I catch pubic lice from shared gym shorts or boxers?
Yes. Pubic lice can cling to fibers and transfer from one person to another through shared clothing, especially tight-fitting garments like underwear or swim trunks.
7. Do I need to get tested after sharing underwear?
If you notice itching, bumps, or a rash, absolutely. Even if you feel fine, a quick check with an at-home STD test kit can give you peace of mind.
8. Will washing underwear at home kill everything?
Only if you use hot water (130°F/54°C) and high-heat drying. Cold or warm washes don’t always kill parasites or fungi.
9. Can I get HPV or HIV from underwear?
No. Those viruses require direct contact with mucous membranes or bodily fluids. They don’t survive long outside the body and aren't transmitted via fabric.
10. What’s the safest way to loan someone underwear if I have to?
Honestly? Don’t. But if it’s unavoidable, give them a freshly laundered, never-worn pair. And have them return it unwashed so you can sanitize it properly before using it again (or just toss it).
Order Now $33.99 $49.00 Check Your STD Status in Minutes
Test at Home with Remedium
Chlamydia Test Kit




Final Word , Don’t Let Dirty Laundry Turn Into a Dirty Secret
Here’s the bottom line: Underwear is intimate. Period.
It might seem like a harmless act of friendship or a convenience during travel, but sharing underwear carries real health risks, from itchy infestations to highly contagious skin infections. And the worst part? People rarely see it coming. We’ve been taught to be careful with sex, but not with our shorts. That ends today.
If you’ve shared underwear recently, or if you’re dealing with weird symptoms that don’t seem to make sense, get tested discreetly from home with a rapid STD test kit. You deserve answers without judgment. You deserve peace of mind.
Let this be the article you read before you say, “Sure, I’ll borrow a pair.” Let this be the knowledge you pass on when someone shrugs and says, “It’s just underwear.” Because in the world of sexual health, “just underwear” is never just underwear.
Sources
1. Sex and Travel – CDC (tripling of STI risk with casual sex abroad; pack condoms)
2. Pre-travel advice linked to lower STI risk among travelers – PMC
3. Can You Get an STD Through Clothing? – MedicineNet (pubic lice, scabies, but not typical STIs)
5. Trichomoniasis – ASHA (including survival on damp fabric; non-sex infection possible)










